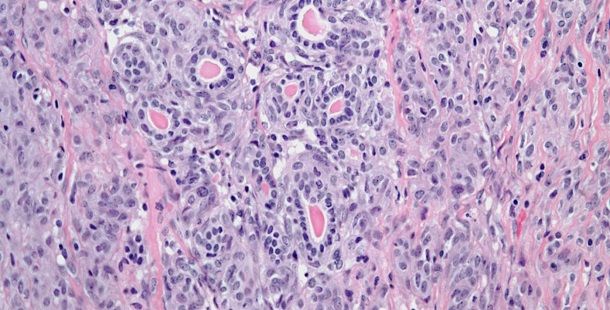

Kidney Cancer
Latest News
Latest Videos

CME Content
More News

Clinical response can be challenging to predict in some cancers, but new research has shown the ability to predict response to sunitinib (Sutent) in patients with advanced renal cell carcinoma (RCC).

According to the AREN0532 and AREN0533 trials, adding additional drugs to a therapy regimen for Wilms tumor in children with high-risk disease improved outcomes.

A 42-year-old woman is found to have a cystic tumor in the kidney. What is your diagnosis?

A 43-year-old woman presents with pain in the right flank. A kidney mass is found on imaging. What is your diagnosis?

This oncology drug snapshot takes a look at axitinib (Inlyta) for the treatment of advanced renal cell carcinoma (RCC) after failure of one prior systemic therapy.

A 69-year-old man presented in the urology clinic for evaluation of bilateral renal masses, discovered incidentally during routine exams for follow-up of his chronic kidney disease.

A 20-year-old man is found to have an abnormality on imaging. A biopsy is performed. What is your diagnosis?

Metastatic renal cell carcinoma patients with an elevated neutrophil-to-lymphocyte ratio at baseline had inferior outcomes compared to those with a low ratio.

This slide show features various images of papillary, clear cell, chromophobe, and tubulocystic renal cell carcinoma.

A 38-year-old man presents with hematuria. A kidney mass is detected by imaging. Based on the shown biopsy, what is your diagnosis?

A 67-year-old man presents with hematuria and a kidney mass found on imaging. After further evaluation, a biopsy is performed. What is your diagnosis?

A full-term infant presents with abdominal distention and enlarged kidneys. After further evaluation, a biopsy is performed. What is your diagnosis?

If physicians are following the current NCCN and AUA renal cell carcinoma surveillance guidelines, they could be missing as many as one-third of recurrences.

Cancer survivors are at an increased risk for developing a second smoking-associated cancer if they smoked cigarettes prior to their first cancer diagnosis.

In this edition of our ongoing series, the authors present two cases involving renal cell carcinoma patients treated with SBRT for pancreatic metastases.

Participants from two separate studies with higher levels of vitamin B6 were found to have a lower risk for renal cell carcinoma.

An increased intake of lycopene may be associated with a decreased risk for renal cell carcinoma, according to data from a study of postmenopausal women.

Partial nephrectomy may be just as effective as radical nephrectomy for the surgical removal of clinical T2 renal masses, results of a new study indicate.

Marked differences in renal cell carcinoma subtype were observed by race and sex in patients who underwent nephrectomy at a large tertiary care academic center.

Children treated for Wilms tumor, a rare kidney cancer, with chest radiation may be at a higher risk for developing breast cancer in adulthood.

An external validation study has confirmed that biomarkers of the mTOR pathway have prognostic value in patients with clear cell renal cell carcinoma.

In patients with non–clear cell RCC, PD-L1 positivity is associated with worse clinical outcomes, including a shorter overall survival and time to recurrence.

Results of a new study show that cancer rates among children and adolescents are stable, but rates of certain cancers such as renal carcinomas are increasing.

A 71-year-old woman presented with back pain and was incidentally found to have a left upper pole renal mass. She underwent left open partial nephrectomy; the pathology results revealed a 2.2-cm clear-cell renal cell carcinoma (RCC) with negative margins and a Fuhrman nuclear grade of 2.

Patient exposure to metformin before undergoing nephrectomy for renal cell carcinoma may have an effect on patient survival, according to a new study.